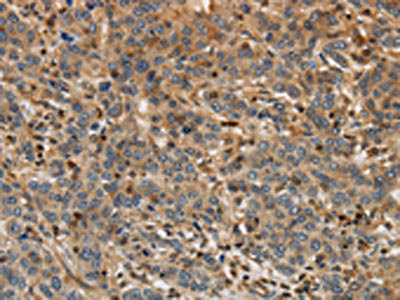

ARF6 Antibody
-
中文名稱:ARF6兔多克隆抗體
-
貨號(hào):CSB-PA129669
-
規(guī)格:¥1100
-
圖片:
-
The image on the left is immunohistochemistry of paraffin-embedded Human liver cancer tissue using CSB-PA129669(ARF6 Antibody) at dilution 1/30, on the right is treated with synthetic peptide. (Original magnification: ×200)
-
The image on the left is immunohistochemistry of paraffin-embedded Human brain tissue using CSB-PA129669(ARF6 Antibody) at dilution 1/30, on the right is treated with synthetic peptide. (Original magnification: ×200)
-
Gel: 8%SDS-PAGE, Lysate: 40 μg, Lane 1-5: Hela cells, 293T cells, mouse liver tissue, A431 cells, MCF7 cells, Primary antibody: CSB-PA129669(ARF6 Antibody) at dilution 1/450, Secondary antibody: Goat anti rabbit IgG at 1/8000 dilution, Exposure time: 40 seconds
-
-
其他:
產(chǎn)品詳情
-
Uniprot No.:
-
基因名:
-
別名:ADP ribosylation factor 6 antibody; ADP ribosylation factor protein 6 antibody; ADP-ribosylation factor 6 antibody; ARF6 antibody; ARF6_HUMAN antibody; DKFZp564M0264 antibody; Small GTP binding protein antibody; Small GTPase antibody
-
宿主:Rabbit
-
反應(yīng)種屬:Human,Mouse,Rat
-
免疫原:Synthetic peptide of Human ARF6
-
免疫原種屬:Homo sapiens (Human)
-
標(biāo)記方式:Non-conjugated
-
抗體亞型:IgG
-
純化方式:Antigen affinity purification
-
濃度:It differs from different batches. Please contact us to confirm it.
-
保存緩沖液:-20°C, pH7.4 PBS, 0.05% NaN3, 40% Glycerol
-
產(chǎn)品提供形式:Liquid
-
應(yīng)用范圍:ELISA,WB,IHC
-
推薦稀釋比:
Application Recommended Dilution ELISA 1:2000-1:5000 WB 1:500-1:2000 IHC 1:25-1:100 -
Protocols:
-
儲(chǔ)存條件:Upon receipt, store at -20°C or -80°C. Avoid repeated freeze.
-
貨期:Basically, we can dispatch the products out in 1-3 working days after receiving your orders. Delivery time maybe differs from different purchasing way or location, please kindly consult your local distributors for specific delivery time.
-
用途:For Research Use Only. Not for use in diagnostic or therapeutic procedures.
相關(guān)產(chǎn)品
靶點(diǎn)詳情
-
功能:GTP-binding protein involved in protein trafficking that regulates endocytic recycling and cytoskeleton remodeling. Required for normal completion of mitotic cytokinesis. Plays a role in the reorganization of the actin cytoskeleton and the formation of stress fibers. Involved in the regulation of dendritic spine development, contributing to the regulation of dendritic branching and filopodia extension. Plays an important role in membrane trafficking, during junctional remodeling and epithelial polarization. Regulates surface levels of adherens junction proteins such as CDH1. Required for NTRK1 sorting to the recycling pathway from early endosomes.; (Microbial infection) Functions as an allosteric activator of the cholera toxin catalytic subunit, an ADP-ribosyltransferase.
-
基因功能參考文獻(xiàn):
- Data show that the ADP-ribosylation factor 6 (Arf6)-trafficking kinesin protein 1 (trak1) promote the anterograde trafficking of mitochondria. PMID: 29992963
- Structural dynamics control allosteric activation of Grp1 and ARF6. PMID: 29276036
- Arf6 appears to be necessary for both RhoA- and Rac1-driven cancer invasion PMID: 27754741
- By means of reducing the expression of Arf6 and subsequent signal transduction via NF-kappaB, miR-145 plays a role in inhibiting the secretion of inflammatory factors and then improving the inflammatory status. PMID: 29388044
- In Jurkat cells, the activities of two guanine nucleotide binding proteins, Arf6 and Rab22 (also known as Rab22a), influence CIE and conjugate formation. PMID: 28584192
- The Arf6 is of particular interest,since it is believed to play a regulatory role in several cellular physiological functions, including cell-cell interactions(adhesiveness), motility, shape maintenance, and responses to environmental stimuli via cytoskeletal adaptations and vesicular trafficking. PMID: 29119258
- computational study suggests that although curcumin to some extent binds with Tp receptor, yet the inhibition of Arf6GDP to Arf6GTP conversion appeared to be an important mechanism by which curcumin inhibits U46619-induced increase in PLD activity in PASMCs. PMID: 28780751
- This study identifies a novel regulatory crosstalk between Ral and Arf6 that controls Ral function in cells. PMID: 27269287
- ARHGAP24 may regulate pseudopod formation downstream of activated ARF6 in MDA-MB-231 human breast carcinoma cells. PMID: 28870903
- ARF6 was a downstream target of Kras/ERK signaling pathway, and the strong correlation of expression between Kras and ARF6 in the TCGA dataset further confirmed this observation. PMID: 28025100
- FRMD4A RNAi or inhibition of cytohesins strongly upregulated secretion of endogenous tau. These results suggest that FRMD4A, a genetic risk factor for late-onset Alzheimer's disease, regulates tau secretion by activating cytohesin-Arf6 signaling. PMID: 27044754
- Macrophage tissue factor prothrombotic activity is regulated by integrin-alpha4/arf6 trafficking. PMID: 28495929
- Here the authors report that EspG interacts specifically with the small GTPases ARF6 and Rab35 during infection. PMID: 27261256
- These results identify RalF as the first bacterial effector to directly activate Arf6, a process that initiates alterations in phosphoinositol metabolism critical for a lineage-specific Rickettsia entry mechanism. PMID: 27698019
- Data suggest that activated ARF6 controls GNAQ and b-catenin signaling by regulating protein trafficking between intracellular compartments. Blocking ARF6 with a small-molecule inhibitor reduces uveal melanoma cell proliferation and tumorigenesis in a mouse model. PMID: 27265506
- expression and activation of LHCGR and ARF6 are up-regulated in GC from PCOS women but the mechanism of agonist-induced LHCGR internalization is unaltered PMID: 27061682
- The Squamous cell carcinoma of the tongue cell line SCC-9, which overexpress Arf6 and AMAP1, also expressed EPB41L5 at high levels to promote invasiveness, whereas the weakly invasive SCC-25 cells did not express EPB41L5 at notable levels. PMID: 27871329
- both Arf6 activation through GluN2B-BRAG1 during early development and the transition from BRAG1- to BRAG2-dependent Arf6 signaling induced by the GluN2 subunit switch are critical for the development of mature glutamatergic synapses. PMID: 26884337
- results provide evidence for a novel Arf6 activation mechanism by Dyn2 through EFA6B and EFA6D in CME in a manner dependent upon the GTPase activity of Dyn2 PMID: 26503427
- Mutant p53, which is known to support tumorigenesis via MVP, promotes Arf6 activation. PMID: 27044891
- The expression of miR-206 by HUVECs reduced exosome production by regulating ADP-Ribosylation Factor 6 (ARF6) and sodium/calcium exchanger 1 (NCX1). PMID: 27031991
- The role of EGFR-ARF6 signaling in BA. PMID: 26379158
- Data suggest ADAP2 (an interferon-beta stimulated gene) disrupts pathogenic internalization of some RNA viruses/virions (dengue, vesicular stomatitis) by altering ADP ribosylation factor 6-mediated processes including up-regulation of pinocytosis. PMID: 26372645
- Results show that miR-145 directly targets the 3'UTR of ARF6 mRNA; its expression is upregulated in triple-negative breast cancer and tumor metastasis. PMID: 25253741
- The authors show that Shigella flexneri IpgD phosphatase activity is required for recruitment of the ARF6 guanine nucleotide exchange factor (GEF) ARF nucleotide binding site opener (ARNO) to bacterial entry sites. PMID: 25736891
- a role for ARF6 in linking EGF-receptor signaling to Rac1 recruitment and activation at the plasma membrane to promote breast cancer cell directed migration PMID: 25799492
- Wnt5a is a potential suppressor of EMT; there is a novel Arf6/ERK signaling pathway for EGF-regulated Wnt5a expression at transcriptional level of gastric cancer cel PMID: 25779663
- Data indicate that exocytic stimuli promote ADP ribosylation factor 6 (ARF6) activation, which accomplishes exocytosis by stimulating Rab3A GTP-Binding Protein. PMID: 25713146
- Formation of the ventral actin structures was enhanced by expression of active forms of either Arf1 or Arf6 and by the expression of guanine nucleotide exchange factors that activate these Arfs. PMID: 24916416
- Arf6 guanine nucleotide exchange factor cytohesin-2 binds to CCDC120 and is transported along neurites to mediate neurite growth. PMID: 25326380
- EFA6R regulated ARF6 localization and thereby actin stress fiber loss. PMID: 25296758
- Cytohesin-2 constitutively suppresses platelet dense granule secretion and aggregation by keeping ARF6 in a GTP-bound state PMID: 24581425
- Syntenin-ALIX exosome biogenesis and budding into multivesicular bodies are controlled by ARF6 and PLD2. PMID: 24637612
- 8 GEFs control Arf6 activation.[review] PMID: 24139303
- The EGFR-GEP100-Arf6 axis affected the prognosis of patients with primary lung adenocarcinoma. PMID: 24902879
- hERG undergoes clathrin-independent endocytosis via a mechanism involving Arf6 PMID: 24392021
- MyD88-ARNO-ARF6-signaling axis is responsible for LPS-induced endothelial permeability and is a destabilizing convergence point used by multiple inflammatory cues PMID: 24835390
- Data indicate that tumor necrosis factor-alpha (TNF) abolishes nuclear localization of IL-15 and IL-15Ralpha by acting on chromosomal region maintenance 1 (CRM1), and it facilitates exocytosis of IL-15 with the involvement of ADP-ribosylation factor 6 (ARF6). PMID: 23950892
- SMAP1 loss-of-function mutations in microsatellite instability colorectal cancer may contribute to the emerging oncogenic pathway involving abnormal Arf6 regulation. PMID: 23752192
- FilGAP may function as a mediator of the regulation of Rac by Arf6. PMID: 24526684
- The CYTH2 and ACTN1 properly regulates neurite extension in N1E-115 cells, demonstrating the unexpected interaction of CYTH2 and ACTN1 in the regulation of cellular Arf6 activity involved in neurite extension. PMID: 22659138
- This study reconstitutes Arf6-dependent actin assembly to reveal a mechanism by which related Arf GTPases orchestrate distinct steps in the WRC cytoskeleton remodelling pathway. PMID: 24085844
- mutual regulation with Rab35 of cell adhesion and migration PMID: 23264734
- The results thus show that ARF6 regulates neuronal differentiation through an effect on glucosylceramide synthase and glucosylceramide levels. PMID: 23555901
- ARF6 may provide a means of inhibiting WNT/beta-catenin signaling in cancer PMID: 23462101
- EFA6 participates in activation of Arf6 around the cleavage furrow during cytokinesis. PMID: 23603394
- Our studies implicate the small regulatory GTPase Arf6 in the endocytic trafficking of Pasteurella multocida toxin. PMID: 22053287
- Arf6/ ARNO signaling mediates phospholipase-D, ERK1/2 and cofilin activation in pancreatic beta-cells. PMID: 23095975
- ARAP2 signals through Arf6 and Rac1 to control focal adhesion morphology PMID: 23295182
- GRASP regulates the non-clathrin/Arf6-dependent, plasma membrane recycling and signalling pathways. PMID: 22931251
顯示更多
收起更多
-
亞細(xì)胞定位:Cytoplasm, cytosol. Cell membrane; Lipid-anchor. Endosome membrane; Lipid-anchor. Recycling endosome membrane; Lipid-anchor. Cell projection, filopodium membrane; Lipid-anchor. Cell projection, ruffle. Cleavage furrow. Midbody, Midbody ring. Early endosome membrane; Lipid-anchor. Golgi apparatus, trans-Golgi network membrane; Lipid-anchor.
-
蛋白家族:Small GTPase superfamily, Arf family
-
組織特異性:Ubiquitous, with higher levels in heart, substantia nigra, and kidney.
-
數(shù)據(jù)庫鏈接:
Most popular with customers
-
-
YWHAB Recombinant Monoclonal Antibody
Applications: ELISA, WB, IHC, IF, FC
Species Reactivity: Human, Mouse, Rat
-
Phospho-YAP1 (S127) Recombinant Monoclonal Antibody
Applications: ELISA, WB, IHC
Species Reactivity: Human
-
-
-
-
-